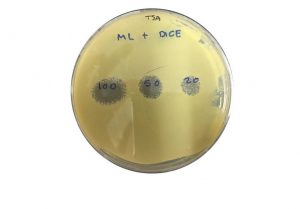

Un equipo de la Unidad de Mejora Genética de Organismos Fotosintéticos de la Universidad de Huelva ha aplicado moléculas del mismo sistema inmune de los peces como ‘fármacos’ para reducir en acuicultura el uso de antibióticos. Los nuevos compuestos actúan contra un espectro más amplio de patógenos, son más amigables con el medio ambiente, y reducen la resistencia a los antibióticos que manifiestan las especies criadas en cautividad. Los expertos estudiaron 15 bacterias y 4 de los virus más devastadores en acuicultura. Todos se inhibieron en distinta medida por los péptidos testados. “Nuestras conclusiones indican que estos compuestos funcionan bien como agentes terapéuticos en la lucha contra las enfermedades en peces, tanto bacterianas como víricas”, indica Marta Vila, investigadora de la UHU.
Un equipo de la Unidad de Mejora Genética de Organismos Fotosintéticos de la Universidad de Huelva ha aplicado moléculas del mismo sistema inmune de los peces como ‘fármacos’ para reducir en acuicultura el uso de antibióticos. Los nuevos compuestos actúan contra un espectro más amplio de patógenos, son más amigables con el medio ambiente, y reducen la resistencia a los antibióticos que manifiestan las especies criadas en cautividad. Los expertos estudiaron 15 bacterias y 4 de los virus más devastadores en acuicultura. Todos se inhibieron en distinta medida por los péptidos testados. “Nuestras conclusiones indican que estos compuestos funcionan bien como agentes terapéuticos en la lucha contra las enfermedades en peces, tanto bacterianas como víricas”, indica Marta Vila, investigadora de la UHU.
Estas moléculas forman parte del sistema inmunitario propio de la mayoría de los organismos vivos. “Tienen demostrada su actividad frente a un amplio espectro de micro-organismos, como bacterias u hongos, pero hasta ahora su aplicación como fármacos para la acuicultura no estaba explorada”, señala Marta Vila, autora del estudio ‘Exploring small cationic peptides of different origin as potential antimicrobial agents in aquaculture’, publicado en la revista Fish and Shellfish Immunology.
El estudio se centra en un problema del sector: muchos patógenos aumentan su resistencia a los antibióticos, lo cual limita el uso masivo de estas sustancias, como viene siendo la práctica habitual en ganadería y acuicultura para compensar los problemas que ocasiona el hacinamiento de los especímenes.
El ensayo de la actividad antibacteriana y antiviral de los péptidos estudiados lo realizaron los científicos in vitro, en cultivos de laboratorio. “Una de las ventajas de estos péptidos antimicrobianos es que resultan eficaces frente a un amplio espectro de patógenos, no sólo frente a bacterias, como le ocurre a los antibióticos”, indica Marta Vila. Además, al ser producidos de forma natural por especies autóctonas, como lubina o rana, ofrecen ventajas. Entre ellas no perjudicar el medio ambiente, carecer de peligro de diseminación al entorno y no generar el riesgo de que las bacterias se hagan resistentes a ellos, añade la investigadora.
La experta señala que se trata de un sector que ya supone el 47% del pescado consumido a escala mundial, como indica el informe de 2019 de la Organización de las Naciones Unidas para la Agricultura y la Alimentación (FAO). Esta magnitud provoca que los brotes infecciosos en acuicultura causen cada año pérdidas superiores a 10.000 millones de dólares, según datos de la misma organización.
MÁS ECONÓMICO
El siguiente reto que se marca el equipo de investigación se centra en producir en grandes cantidades los péptidos de forma más económica, lo cual les permitirá acometer estudios con animales. Este proceso se encuentra ya en marcha mediante la producción de los péptidos en microalgas y en bacterias.
Con más volumen e péptidos elaborado, los ensayos in vivo probarán diferentes formas de suministro a las especies acuícolas. “Nuestro objetivo es desarrollar métodos para el suministro oral, que es mucho más fácil que la vía parental, sobre todo en especímenes de pequeño tamaño, como alevines o juveniles”, afirma Marta Vila.
El estudio se financia a través de un proyecto I+D+i del anterior Ministerio de Ciencia, Innovación y Universidades, coordinado por investigadores del Departamento de Biología celular e Histología de la Universidad de Murcia; en el que también participa la Universidad Pontifica de Católica de Valparaíso (Chile).
